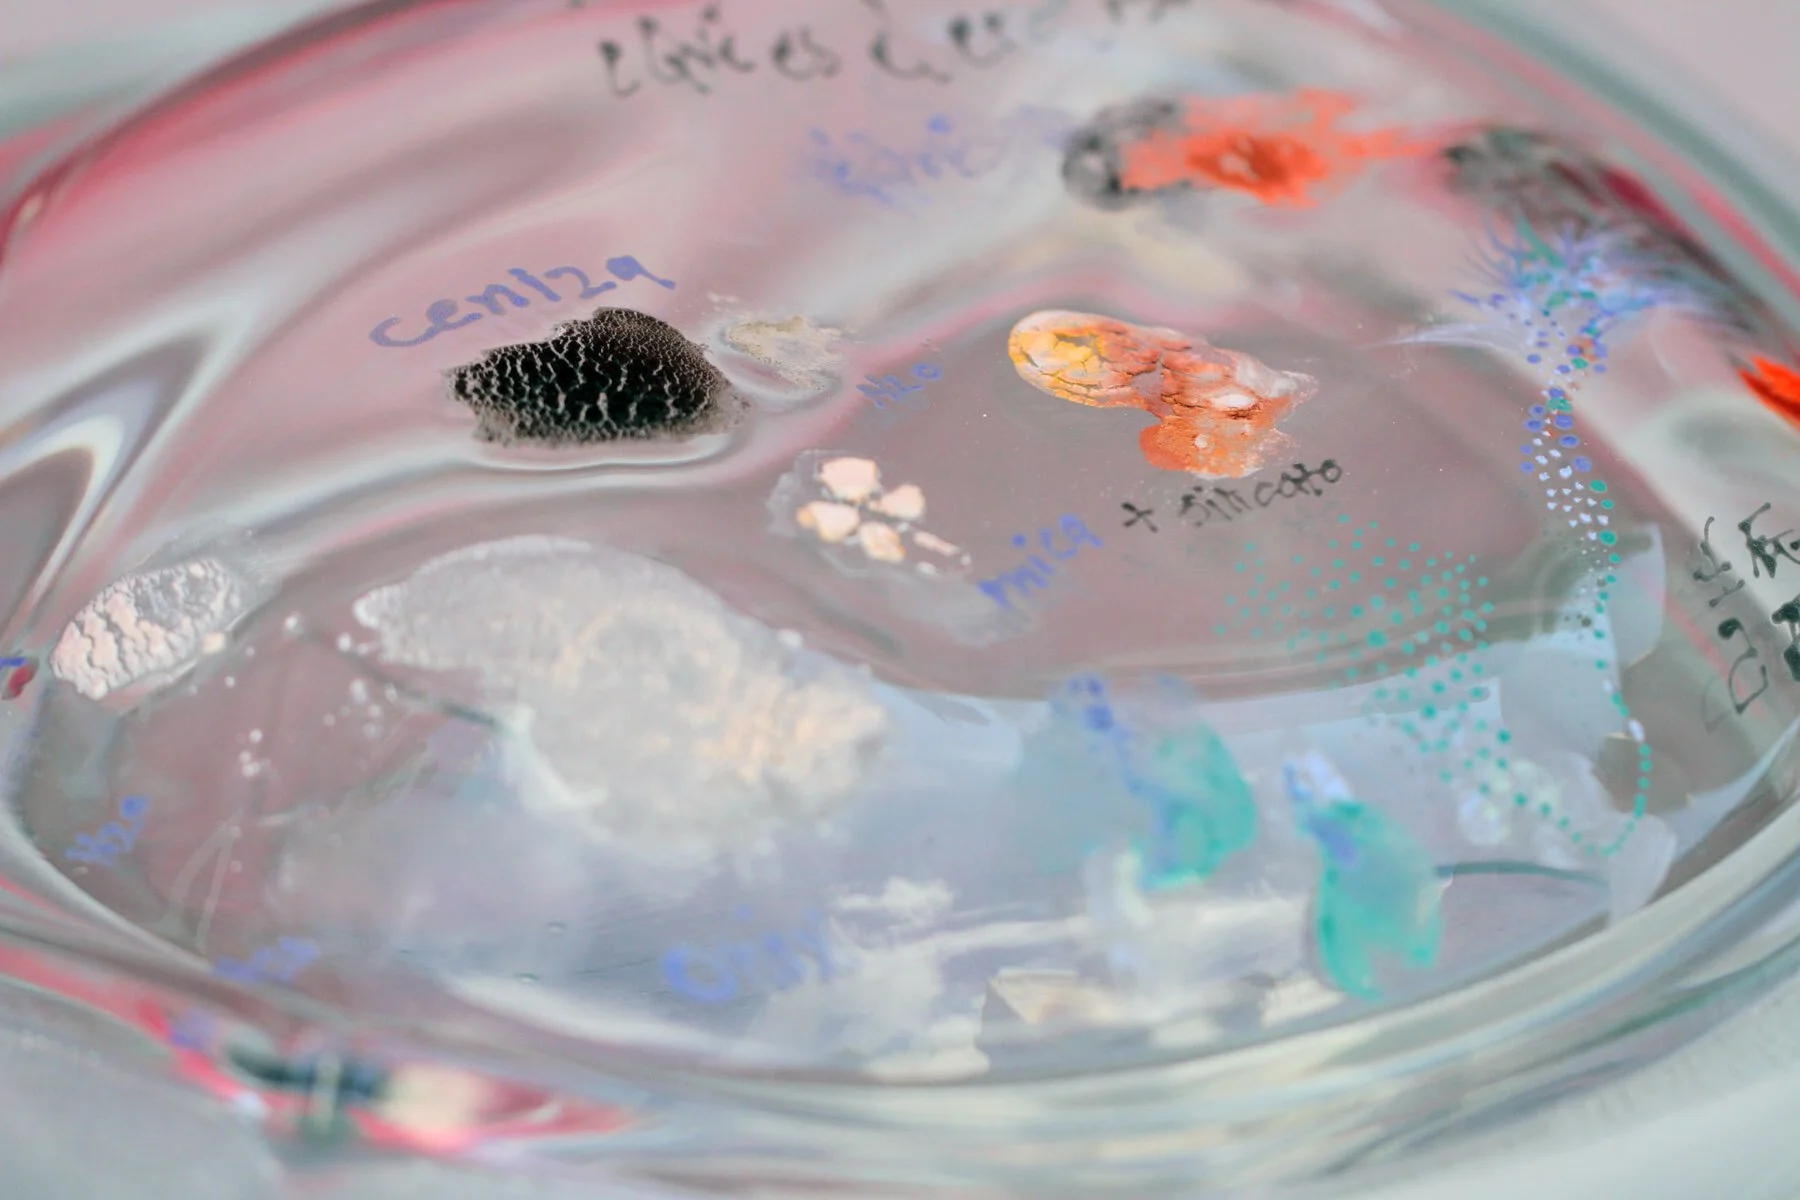

glass works
Vidrio horneado
20 x 20 cms
64 Hexagramas del I Ching + Lo posible más allá de lo probable. Hornear el ciclo de probabilidades para entrever otras posibilidades.
“Quiero ir más allá de lo probable, porque lo posible es más interesante para mí. Y lo posible está contenido en la ruptura de la abstracción y en el dramático retorno del cuerpo concreto como portador de necesidades concretas” *. |Franco Bifo Berardi